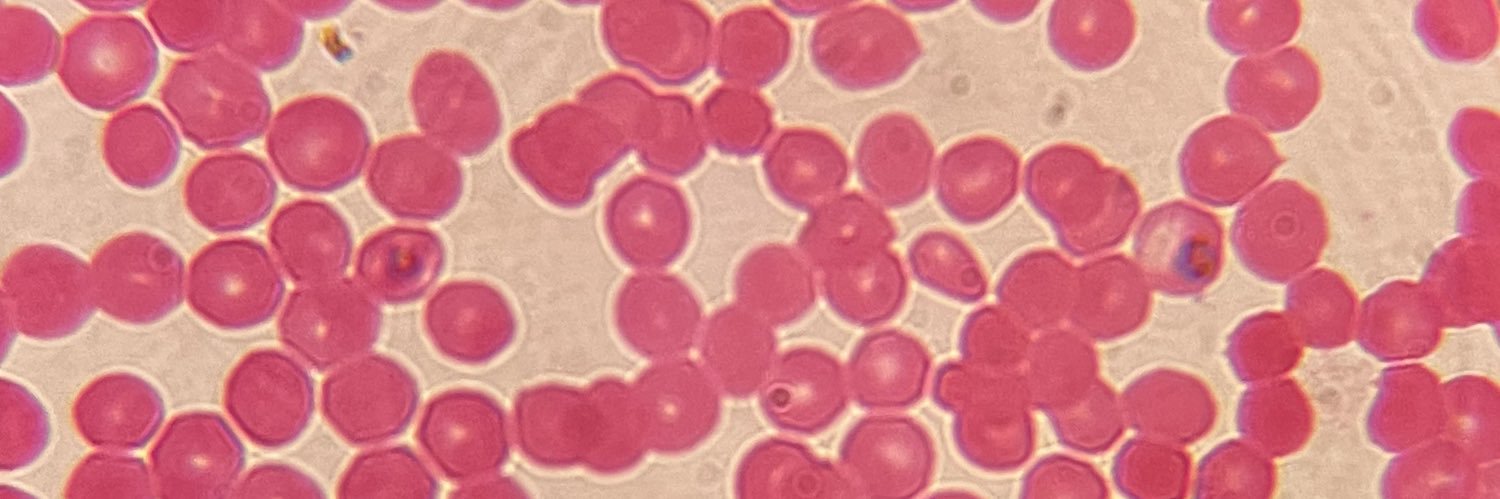
yisus correa banner

yisus correa
1.3K posts


yisus correa
@jsscoca1
el Ultimo guerrero de Dios con carnet| Motril
Motril, España Katılım Ocak 2020
119 Takip Edilen98 Takipçiler
yisus correa retweetledi
yisus correa
1.3K posts

@jsscoca1
el Ultimo guerrero de Dios con carnet| Motril